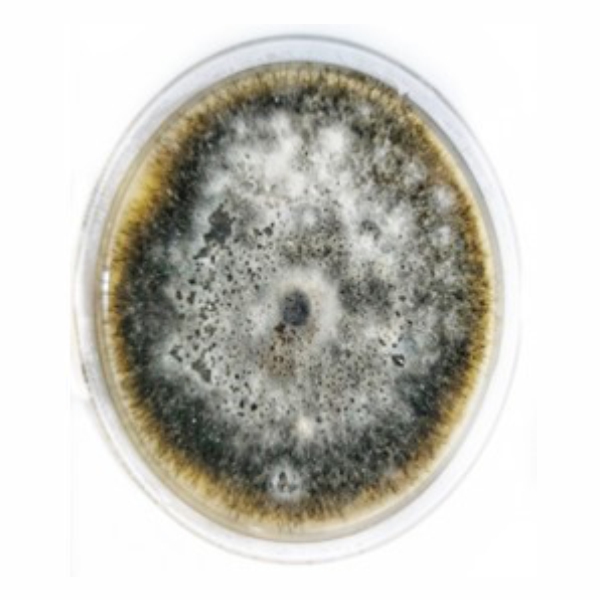
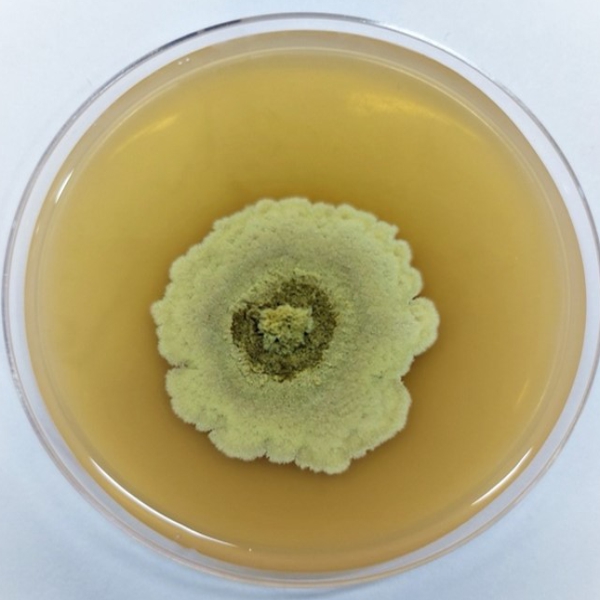
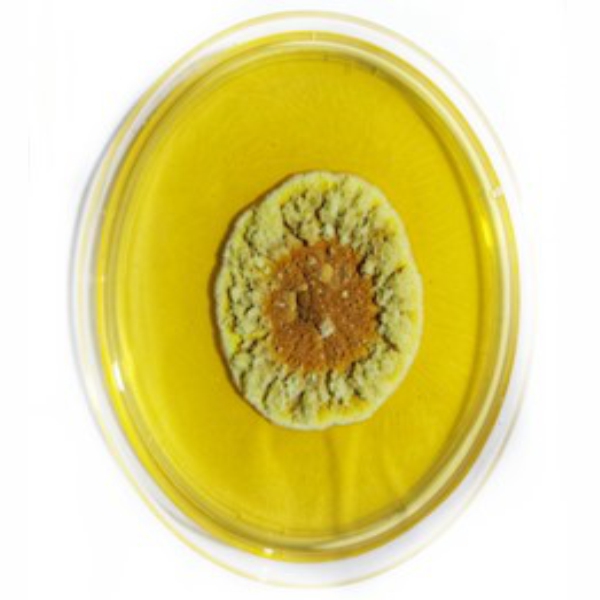

Research And Development
We have seven in-house R&D laboratories, comprising (i) entomology laboratory situated in Ambala, Haryana, India, (ii) plant pathology laboratory situation in Ambala Unit I, (iii) formulation development laboratory (which is accredited with the Department of Scientific and Industrial Research (“DSIR”)) situated in Ambala Unit 2, (iv) process development laboratories situated in Cuddalore Unit, which is DSIR approved physical and chemical testing laboratory (which is accredited with the National Accreditation Board for Laboratories (“NABL”)) situated in Ambala Unit 2, (iv) physical chemical testing lab in Vadodara Unit which is a ISO 9001 certified, (v) ; and (vii) packaging development laboratory situated in Ambala Unit 2. Our in-house R&D laboratories are further supported by six dedicated scientific departments (focussed on various aspects of our operations, including quality control, training, and health, safety and environment). We also have two trial farms situated in Ambala, Haryana, India and Aurangabad, Maharashtra, which are utilized for field trials to determine practical efficacy of products. As on June 30, 2025, we have 59 technically qualified employees, including entomologists, toxicologists, biotechnologists, agronomists, microbiologists, and chemists across these departments. This includes 11 PhDs holders in their respective areas of specialization.
Our Research And Development Laboratories
Entomology laboratory
The entomology laboratory conducts year-round bio-efficacy studies of insecticides on pests using insect cultures reared on artificial diets. This approach supports the development of effective pest management strategies through scientifically sound evaluations.


Plant pathology laboratory
The plant pathology laboratory conducts bio-efficacy trials on over 20 plant pathogens, ensuring year-round availability for controlled product testing. Equipped with advanced instruments, the lab contributes to sustainable crop protection solutions.

The formulation development laboratory designs and optimizes innovative product formulations for safe, effective, and sustainable delivery of active ingredients. Key activities include exploring various formulation types, reducing solvent use, and integrating adjuvants for improved efficacy and crop safety.
Process Development Laboratory
Process R&D focuses on developing safe, efficient, and scalable manufacturing processes for active ingredients and intermediates. The team works on route selection, process optimization, and cost-effective scale-up while ensuring product quality and yield.
Research Farms Of R&D Agriculture
Parijat has established 2 research farms to validate laboratory findings under actual field scenarios.
- Kshitij Research Farm: This research centre in located in Tasrauli village Ambala, Haryana, with the land span of 2.5 acres. This research station is equipped with advance agriculture infrastructure like net house, Glasshouse, Drip irrigation system and office step for its scientists.




2. Aurangabad Research Farm: This research station is in Village, Sawangi, Ch. Sambhabjinagar (Aurangabad), Maharashtra, farm spreads within the area of 3 acres. This research farm is equipped with Drip Irrigation, Sprinkler irrigation, a fully dedicated office for the team.






Physical And Chemical Testing Laboratory
Physical-chemical testing laboratories ensure product quality and regulatory compliance by testing parameters like appearance, pH, and stability. Equipped with advanced instruments, these labs support product reliability and safety.
Packaging Development Laboratory
Packaging development lab ensures product stability, safety, and ease of handling throughout its shelf life. It selects appropriate materials like HDPE, Co-Ex, PET, laminated pouches, metal cans, or bulk containers chemically compatible with the formulation, resistant to leakage, corrosion, and environmental stress. Our development focuses on designing user-friendly packs with accurate dosing, tamper evidence, and safe disposal options, meeting regulatory and sustainability requirements. Quality control includes rigorous testing for container integrity, sealing strength, permeability, stress cracking, drop resistance, and compatibility with the product under storage conditions. These controls preserve product quality, protect users, facilitate transportation, and minimize environmental impact. Our lab is equipped with top-class instruments like bursting strength and stack load testing to fulfill all testing parameters during packaging development.
Further Our Company intensively work and collaborate with a gamut of universities and scientific institutions including 11 state agricultural universities covering almost all the agro-ecological zones for bio-efficacy data generation.
Research And Development
We have seven in-house R&D laboratories, comprising (i) entomology laboratory situated in Ambala, Haryana, India, (ii) plant pathology laboratory situation in Ambala Unit I, (iii) formulation development laboratory (which is accredited with the Department of Scientific and Industrial Research (“DSIR”)) situated in Ambala Unit 2, (iv) process development laboratories situated in Cuddalore Unit, which is DSIR approved physical and chemical testing laboratory (which is accredited with the National Accreditation Board for Laboratories (“NABL”)) situated in Ambala Unit 2, (iv) physical chemical testing lab in Vadodara Unit which is a ISO 9001 certified, (v) ; and (vii) packaging development laboratory situated in Ambala Unit 2. Our in-house R&D laboratories are further supported by six dedicated scientific departments (focussed on various aspects of our operations, including quality control, training, and health, safety and environment). We also have two trial farms situated in Ambala, Haryana, India and Aurangabad, Maharashtra, which are utilized for field trials to determine practical efficacy of products. As on June 30, 2025, we have 59 technically qualified employees, including entomologists, toxicologists, biotechnologists, agronomists, microbiologists, and chemists across these departments. This includes 11 PhDs holders in their respective areas of specialization.
Our Research And Development Laboratories
Entomology laboratory
The entomology laboratory is dedicated to conduct in-house bio-efficacy studies of various insecticides on pests which enables us to carry out round the year evaluation of new product development though continuous bio-assay trials. Our entomology laboratory maintains insect culture, which are reared within the laboratory on artificial diet allowing precise bio-efficacy testing of insecticides and thereby supporting the development of effective and reliable pest management strategies. It enables us to carry out different type of studies required for insecticide development such as screening of various combinations, standardisation of optimum dose, bio-assay evaluation on products on various pests. By integrating artificial diet-based rearing with systematic bioassays, our entomology laboratory ensures scientifically sound evaluation of insecticides and contributes to the development of sustainable pest control solutions.
Plant Pathology Laboratory
The plant pathology laboratory is dedicated to carry out bio-efficacy trials on various plant pathogens. In this laboratory, we work on more than 20 different plant pathogens, ensuring extensive testing on these pathogens, which are the disease casual organism across multiple crops in the field condition. We maintain 20 plant pathogen species which are collected from field, isolated, subculture and then continuously maintained on our respective growth medias, to ensure the availability of pathogen throughout the year thereby ensuring product testing is in controlled conditions. This laboratory is equipped with advanced instruments such as laminar airflow, autoclave, bod incubator, microscopes, hot air oven. Our plant pathology laboratory ensures reliable results and contributes significantly to developing sustainable crop protection solutions.
Formulation Development Laboratory
Formulation development laboratory focuses on designing, optimizing, and developing Innovative Product formulations that ensure safe, effective, and sustainable delivery of active ingredients. Key activities include exploring different formulation types such as emulsifiable concentrates, suspension concentrates, water-dispersible granules, microemulsions, and controlled-release systems to enhance product stability, bioavailability, and field performance. Our formulation development laboratory also emphasizes on reducing solvent use, developing eco-friendly carriers, and integrating adjuvants or safeners for improved efficacy and crop safety. Extensive laboratory evaluations, pilot-scale trials, and field testing are carried out to validate stability, shelf-life, efficacy, and regulatory compliance. This laboratory plays a critical role in translating innovative chemistry into user-friendly, high-performance, and sustainable products for customers satisfactions.
Process Development Laboratory
Process R&D is dedicated to developing safe, efficient, and scalable manufacturing processes for active ingredients and intermediates. Activities focus on route selection, process optimization, and cost-effective scale-up while ensuring consistent product quality and yield. Our team is involved in identifying greener and sustainable synthetic pathways, minimizing waste, reducing solvent consumption, and improving energy efficiency in line with environmental and regulatory standards. Process R&D also involves developing robust purification and crystallization techniques, impurity profiling, and safety assessments to ensure regulatory compliance. Scale up studies and technology transfer to commercial manufacturing sites are integral steps, ensuring that laboratory processes are translated into reliable, large-scale production. Overall, process R&D plays a vital role in enhancing manufacturing efficiency, ensuring product consistency, and supporting the sustainable production of technical manufacturing. To date we have commercialized 8 agrochemical molecules in our technical manufacturing plant. Process development of many other new actives are in pipelines.
Research Farms Of R&D Agriculture
Parijat has established 2 research farms to validate laboratory findings under actual field scenarios.
Khistij Research Farm: This research centre in located in Tasrauli village Ambala, Haryana, with the land span of 2.5 acres. This research station is equipped with advance agriculture infrastructure like net house, Glasshouse, Drip irrigation system and office step for its scientists.
This research farm is quipped to carry out various kind of Insecticide, fungicide, herbicide and bio stimulant trials.
Primary findings from this farm enable us to understand the product bio-efficacy at field condition and enable us to carry out multilocation trials for the validation of product efficacy.
Aurangabad Research Farm: This research station is in Village, Sawangi, Ch. Sambhabjinagar (Aurangabad), Maharashtra, farm spreads within the area of 3 acres. This research farm is equipped with Drip Irrigation, Sprinkler irrigation, a fully dedicated office for the team.
This research farm is quipped to carry out various kind of Insecticide, fungicide, herbicide and bio stimulant trials.
Primary findings from this farm enable us to understand the product bio-efficacy at field condition and enable us to carry out multilocation trials for the validation of product efficacy.
Physical And Chemical Testing Laboratory
Our physical-chemical testing laboratories ensure that products meet regulatory standards and perform effectively under field conditions. Key activities include determining parameters such as appearance, color, odor, pH, density, viscosity and moisture content, along with testing particle size distribution, suspensibility, wettability, and stability depending on the formulation type. These tests are critical for assessing formulation stability, product handling, and application characteristics. By simulating practical usage conditions, physical-chemical testing helps verify batch-to-batch consistency, identify deviations, and ensure compliance with FAO/WHO specifications, BIS, CIPAC methods, and other regulatory guidelines. This rigorous testing supports product reliability, farmer safety, and environmental sustainability, forming a cornerstone of agrochemical quality assurance. Our lab is equipped with top class instruments like HPLC, GC, LCMS, Particle Size Analyzer, weighing balance at micrograms etc to fulfill all required testing of phy-chem of the produced batches.
Packaging Development Laboratory
Packaging development lab plays a vital role in ensuring product stability, safety, and ease of handling throughout its shelf life. It involves selecting appropriate materials such as HDPE bottles, Co-Ex bottles, PET bottles, laminated pouches, metal cans, or bulk containers that are chemically compatible with the formulation and resistant to leakage, corrosion, and environmental stress. Our development activities focus on designing user-friendly packs that provide accurate dosing, tamper evidence, and safe disposal options while meeting regulatory and sustainability requirements. Quality control of packaging includes rigorous testing for container integrity, sealing strength, permeability, stress cracking, drop resistance, and compatibility with the product under varying storage conditions. These controls ensure that packaging preserves product quality, protects users, facilitates transportation, and minimizes environmental impact. Overall, robust packaging development and quality control are integral to delivering safe, effective, and sustainable agrochemical products to our customers. Our las is also equipped with top class instruments like busting strengthen, stack load testing etc to fulfill all the required parameters of testing and during packaging development.
